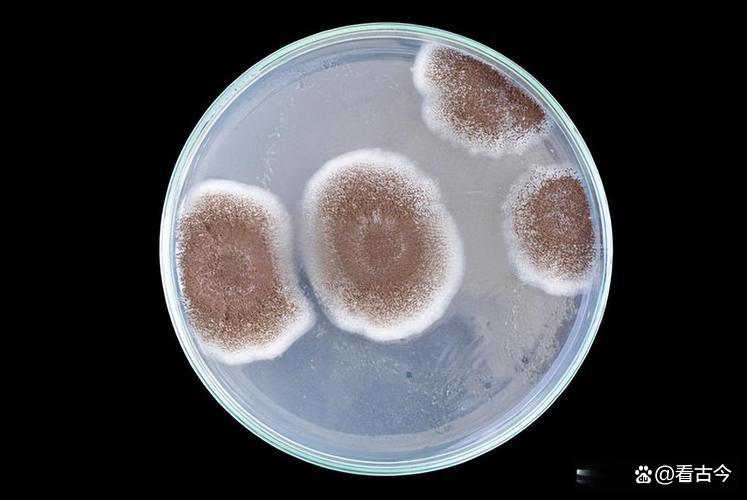
发霉玉米竟成肺部“杀手”?女子接触后肺部全白

发霉玉米竟成“隐形杀手”!两位女性因接触霉变玉米感染肺部霉菌,一度生命垂危。医生提醒:储存粮食务必通风干燥,处理霉变物时需佩戴口罩手套,有呼吸道疾病者更应加强防护。
最近,发霉玉米成了“网红”,不过可不是啥好事儿,它竟然让两位女士的肺部遭了殃,这事儿可太值得唠唠了。

先说说商丘宁陵县的闫先生一家。闫先生的妻子,一位38岁的勤劳农妇,在老家“打玉米”的时候,那可是没少和玉米打交道。谁能想到,这玉米里藏着个“大反派”——霉菌。她当时就感觉头疼、发烧、咳嗽,还以为是小感冒,在诊所输输液就完事儿了。结果呢,输液的时候突然就“翻车”了,说不了话,脸色还发青,这把家人吓得够呛。

赶紧送到医院,商丘市级医院一检查,好家伙,原来是霉菌感染。在当地医院治疗了3天,情况还是不太妙,只能转院到河南省人民医院北院区ICU。这时候,妻子的病情已经相当严重了,确诊为重症肺炎、呼吸衰竭、急性呼吸窘迫综合征,还有侵袭性肺曲霉菌,肺部直接“百分百全白”,就像被一团黑雾给罩住了。医生们那是使出了浑身解数,还动用了ECMO这个“救命神器”,好在现在病情已经好转了,也算是不幸中的万幸。

闫先生岳母猜测,就是收拾那些发霉玉米的时候,霉菌趁机钻进了妻子的肺部。医生也觉得有道理,结合家属的叙述,判断患者长期接触潮湿发霉玉米,很可能吸入了霉菌,而且也不排除和基础病有关。闫先生作为丈夫,那也是心急如焚,赶紧向媒体反映情况,希望能给大家提个醒。

这边商丘的事儿还没消停,湖北武汉又出了一桩类似的事儿。有个23岁的年轻姑娘,回老家帮忙收玉米。这玉米啊,之前淋过雨,都霉坏了,可姑娘没当回事儿,干活的时候也没做任何防护。结果呢,收完玉米1个多月后,就开始咳喘不止,跟拉风箱似的。去医院一检查,肺部长满了黄曲霉菌,直接确诊为真菌感染,这姑娘估计当时都懵了。

武汉市第四医院呼吸与危重症医学科的住院医生郭蒲剑分析说,这姑娘就是接触了黄曲霉菌,又没做防护,才感染上的。看来这发霉玉米,真是个“隐形杀手”,一不小心就中招。

那为啥发霉玉米会有这么大的“威力”呢?河南省人民医院北院区呼吸重症科的副主任医师高帅解释说,粮食这些物品要是不通风、潮湿,堆放时间长了,就容易长霉菌。人要是长期接触,就可能把霉菌吸进肺里,引发感染。
不过大家也别慌,医生们也给出了防护秘籍。首先,储存粮食的时候,得选个通风好的地方,别让它们在潮湿环境里“闷着”。处理可能发霉的物品时,口罩、手套、帽子都得安排上,把自己裹得严严实实的,就像给身体穿了一层“防护甲”。要是家里有人得了肺曲霉菌感染,那得赶紧查找感染源,用含氯消毒剂、酒精给物体表面消消毒,保护好健康人群。特别是那些有呼吸道基础病的朋友,出门可得做好防护,别让霉菌有机可乘。

这两件事儿给咱提了个醒,生活中看似不起眼的小事儿,可能就藏着大隐患。以后处理发霉的东西,可别嫌麻烦,该做的防护一步都不能少。毕竟,身体是革命的本钱,咱可得好好保护着,别让这些“小怪兽”钻了空子。希望大家都能健健康康的,远离这些“隐形杀手”!
本文来自于百家号作者:看古今,仅代表原作者个人观点。本站旨在传播优质文章,无商业用途。如不想在本站展示可联系删除

